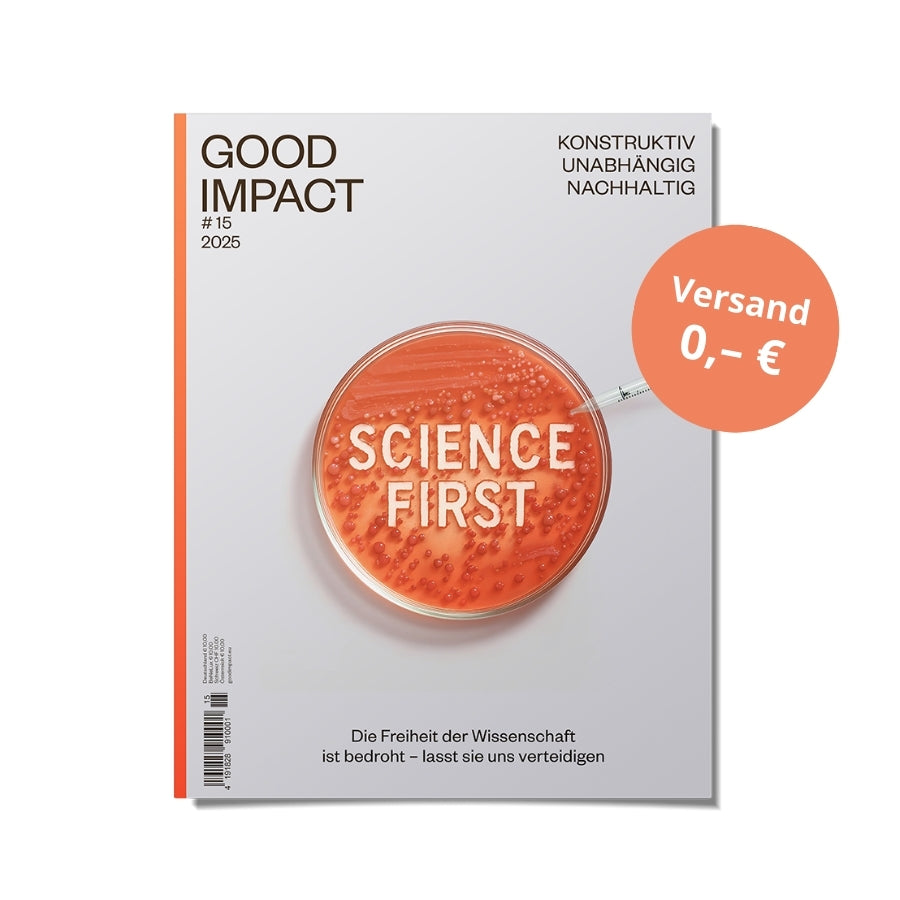

Nachhaltig
Good Impact schreibt nicht nur über nachhaltige Themen: Das Print-Magazin wird so nachhaltig wie möglich gedruckt.
Konstruktiv
Entdecke, wie überall auf der Welt Menschen etwas gegen die Probleme unternehmen. Denn hier liegt der Fokus auf den Lösungen.
Unabhängig
Das Magazin arbeitet unabhängig von Konzernen und Profitmaximierung und finanziert sich über die eigenen Leser*innen.
Das sagt ihr über Good Impact
Leser:innenstimmen
#8 – All you can dream
Tolle Berichte, redaktionell super aufbereitet! Weiter so. Getreu dem Motto: „ Zieht den Vorhang auf, schaut hinter die Kulissen!“
Björn H.
#7 – Demokratie feiern
Ein sehr übersichtliches und informatives Heft! Habt ihr richtig schön gemacht. Danke für eure wertvolle Arbeit, ich bin ein großer Fan
Anonym
#4 – Ecopolis
Sehr informativ, gerade auch für einen Menschen der sich im Bereich Stadtentwicklung gut auskennt.
Falko D.
Konstruktiver Lesestoff als Geschenk
Good Impact Magazin
Geschenk-Abo
Abholung im GoodBuy Store Berlin möglich
Gewöhnlich fertig in 24 Stunden
Geschenk-Abo
GoodBuy Store Berlin
Abholung möglich, gewöhnlich fertig in 24 stunden
Wühlischstraße 15-16
Mo bis Sa: 11 – 19 Uhr
10245 Berlin
Deutschland
Unsere Magazine zum halben Preis
Als Good Member zahlst du nur den halben Preis für unsere Magazine. Unsere Mitgliedschaft kostet nur 5 € im Monat und ist jederzeit kündbar.